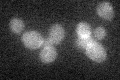
YAL060W
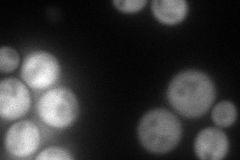
YAL060W
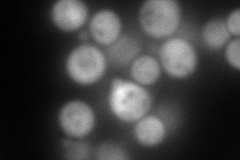
YAL060W
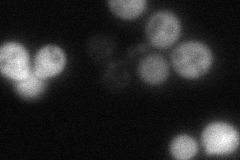
YAL060W
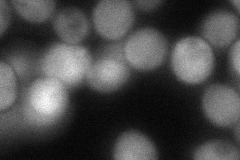
YAL060W
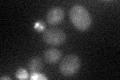
YAL060W

View description
NAD-dependent (R,R)-butanediol dehydrogenase, catalyzes oxidation of (R,R)-2,3-butanediol to (3R)-acetoin, oxidation of meso-butanediol to (3S)-acetoin, and reduction of acetoin; enhances use of 2,3-butanediol as an aerobic carbon source
Localization:
Intensity:
Fold change:
Significance:
-
C’ GFP library in SD
below threshold16.76 -
N' NOP1pr-GFP in SD
cytosol135.038 -
N' TEF2pr-mCherry in SD
cytosol217.528 -
N' NATIVEpr-GFP in SD
cytosol51.3626 -
N' TEF2pr-VC and Cyto-VN in SD
cytosol73.4195 -
C’ GFP library in SD+DTT

cytosol16.390.97No -
C’ GFP library in SD+H2O2

cytosol18.841.12No -
C’ GFP library in Starvation Media
cytosol26.11.55No -
C’ GFP library on the background of Pup2-DaMP

below threshold -
C’ GFP library on the background of CCT mutant

below threshold16.98051.01242No
